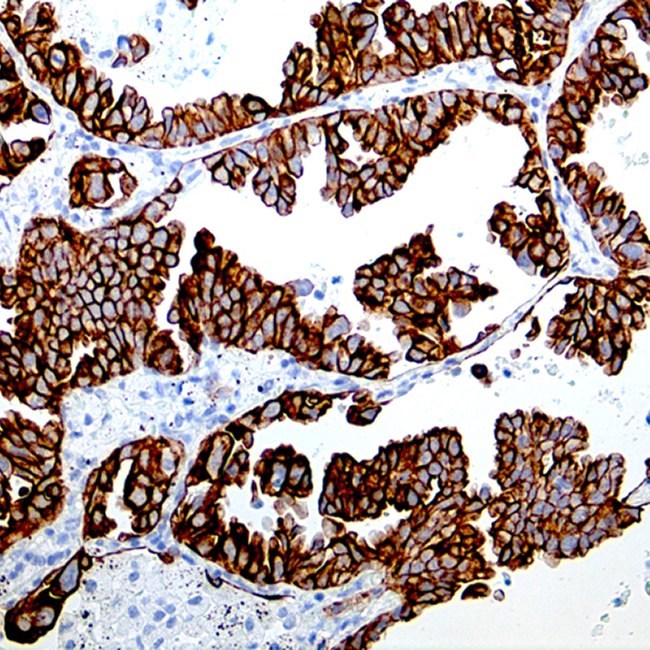

Cytokeratin 7 is expressed in epithelial cells of ovary, lung and breast. It is often used in conjunction with cytokeratin 20 and CDX-2 in distinguishing pulmonary, ovarian and breast carcinomas (CK7+) from most colon carcinomas (CK7-).
0,1 ml
| Clone | LP1K |
| Isotype | IgG1 |
| Application | IHC |
| Host | Mouse |
La documentación estará disponible en breve, mientras tanto, puede contactarnos por correo electrónico a specialist@histoline.com